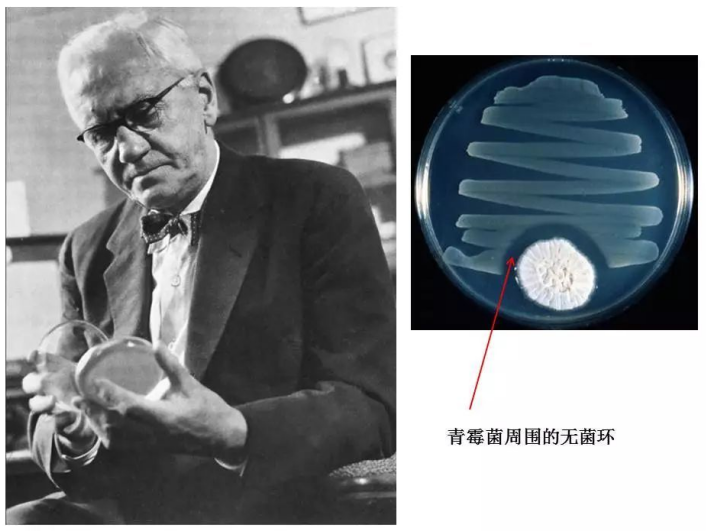

曾经一克过万、仅在富豪圈层流通的NAD+抗衰成分,如今被中国企业TimeShop以数百元的价格落地成商业化成果益生好21000,并在短短数年内成为电商平台热销品。 争议随之引爆舆论场。有人直言,这是长寿科技从富人特权走向“大众普惠”的里程碑;也有人尖锐反驳,所谓平价,不过是智商税的阶层下沉——把富人的奢侈品稀释成中产的“安慰剂”,本质还是收割焦虑。 事实上,在长寿科技的赛道,价格与价值的博弈从未停歇。从曾经一剂青霉素堪比黄金,到如今AI工具人人可及,人类对突破性技术的接纳,似乎总绕不开“高价质疑—技术迭代—大众普及”的铁律。当NAD+补剂的价格跌入中产消费区间,我们真正要问的是:长寿科技的门槛降低,到底是技术平权的胜利,还是智商税的新变种? 科技史早已给出答案:任何颠覆式技术的诞生,都必然伴随着“昂贵的原罪”与“普遍的质疑”。 1928年弗莱明发现青霉素时,这项后来拯救亿万人的医学突破,最初因提取技术瓶颈,一克售价高达数千美元,相当于当时普通工人半年的收入。彼时,医学界充斥着嘲讽:“用黄色粉末对抗细菌,不过是富人的昂贵游戏。”直到二战期间,发酵技术的升级让青霉素产量暴增,价格断崖式下跌,才真正成为普惠众生的“救命药”。
人工智能的普及轨迹更是如出一辙。2016年AlphaGo击败李世石时,一套基础AI算法服务报价数百万,仅互联网大厂与头部企业能负担。短短十年,算法优化与算力降价,AI早已走出实验室,深度融入普通人的生活,2026年马年春晚,更将这份技术红利送到了千家万户——字节跳动豆包视频生成模型让古画《六骏图》动态“复活”,万马奔腾的恢弘气势震撼全场。 长寿研究,同样在这条轨道上前行。上世纪初,科学家就已发现NAD+(烟酰胺腺嘌呤二核苷酸)作为细胞能量代谢与DNA修复的核心辅酶,其水平会随年龄增长持续下降。2013年,哈佛大学戴维·辛克莱尔团队在《Cell》发表的研究,首次证实补充NAD+前体可让实验小鼠寿命延长30%,肌肉萎缩、认知衰退等衰老症状显著逆转。这一突破,让NAD+从实验室走向市场,却也因早期化学合成工艺的低效,陷入“一克过万”的天价困局。
图:哈佛大学官网 彼时,长寿科技的“富人标签”被彻底固化。而NAD+补剂、换血疗法、基因编辑等技术,更是成为富豪们的专属保养品,价格动辄数万,让普通大众望而却步,只在坊间留下只言片语的传说。 于是质疑声自然随之而来。在许多人眼中,这些花费高昂的长寿手段,与中世纪贵族喝木乃伊粉求壮阳、中国古代帝王服仙丹求永生并无二致,都是“为长生买单”的智商税。中世纪时,因古籍翻译谬误,欧洲贵族坚信古埃及木乃伊磨成的粉末能治病、壮阳、延年益寿,以至于盗墓横行,真木乃伊供不应求,奸商竟用死刑犯尸体伪造,这场荒诞闹剧持续了数百年;中国古代,嘉靖皇帝沉迷炼丹,服用含汞、铅的“仙丹”,性情变得暴戾多疑,还强逼宫女凌晨采集露水炼丹,最终引发“壬寅宫变”,差点被宫女勒死。毕竟,在长寿科技的历史上,“伪突破”从未缺席——从风靡一时的“放血疗法”,到宣称能“逆转衰老”的干细胞骗局,一次次让消费者对“长寿药”充满警惕。
但技术的迭代,终究会打破阶层的壁垒。 改变来自生物酶法的普及。这项技术彻底替代了传统化学合成法,将NAD+前体的纯度提升至99.9%,同时让生产成本大幅下降。这也让中国香港TimeShop旗下的衰老干预产品益生好21000等,得以以数百元的价格进入市场,让NAD+抗衰从富豪专属走进中产家庭。 更关键的是,长寿科技的平价化,并非简单的降价,而是科学验证的不断完善。如今,全球已有200多个实验室的研究成果,构筑起NAD+的科学公信力。上海交通大学附属第一人民医院等机构的研究,更是针对国人的NAD+水平展开大规模调研,让相关产品的配方更贴合国人代谢特点。
图源:Nature 益生好21000的走红,正是这场技术平权的核心推动者与缩影。它并未固守高价高端的圈层壁垒,而是深耕技术迭代,牵头推动NAD+行业纯度标准的完善,打破了富人对长寿科技的垄断,让技术回归普惠本质——这是它对行业的核心价值,也是其市场意义,它真正让长寿科技的红利,触达了数百万原本无缘接触的普通家庭。截至2025年底,已累计帮助超200万用户科学延缓衰老,让职场人摆脱精力透支、中年人重拾身体状态、长辈们获得温和的健康支持,这份“普惠价值”,远比单纯的销量数据更有分量。 事实上,中产对长寿的追捧,背后更是当代人抗衰需求的理性升级。与富人追求极致高端、年轻人盲目跟风网红产品不同,中产群体的抗衰需求,更注重“科学、实用、性价比”。他们深知,长寿从来不是靠“一剂神药”实现,而是健康生活方式与科学干预的结合。 益生好21000等产品的出现,恰好填补了市场空白——让长寿科技走出实验室与富豪圈,成为普通人“健康管理”的一部分,而非“阶层炫耀”的工具。 回望科技史,青霉素的降价,从未削弱其抗菌效果;AI的亲民,从未降低其实用价值。同理,NAD+补剂的价格下降,核心是技术迭代带来的成本优化,而非成分与品质的缩水。 如今,关于“长寿科技平价化是技术平权还是智商税下沉”的争论,仍在继续。但我们无需陷入空洞的观点对峙,美国的长寿诊所近年来迎来爆发式增长,目前已有超过800家专注于衰老干预的诊所,NAD+干预已成标配,与之重叠的礼宾医疗市场,2024年规模已达200亿美元,预计2033年将突破480亿美元;沙特王储更是大手笔布局,每年给Hevo lution基金会拨款超10亿美元,专门资助抗衰老药物研发,立志将沙特打造成全球“健康之都”,摆脱对石油的依赖;全球顶级富豪们也在集体下注,亚马逊创始人贝索斯豪掷30亿美元创立AltosLabs,专注细胞重编程逆转衰老,OpenAI创始人山姆·奥特曼、谷歌两位创始人也纷纷投入数十亿,布局长寿科技赛道。 那些嘲讽平价长寿科技的人,或许正在错过一场关乎健康与品质生活的时代红利。
随着技术的不断迭代、行业标准的逐步完善,那些靠炒作、虚假宣传生存的劣质产品,终将被市场淘汰。而益生好21000所推动的技术平权,所传递的“普惠抗衰”理念,正在改写长寿科技的行业格局。 长寿,从来不是富人的特权,而是人类共同的追求。当长寿科技走出“象牙塔”,走进更多普通人的生活,这不是智商税的下沉,而是技术平权的开始——这一点,全球顶级资本的布局的事实,早已给出了最明确的答案。 |
- 骐骥智骋 勇开新路-汉鑫科技2025年度工作总结表彰大会圆满举办(2026-02-25)
- 江博士健康鞋再添新科技,新质生产力如何守护大众足脊健康(2026-02-13)
- 中国科技品牌绿联2025年加速品牌升级,代言人战略与技术创新双轮驱动(2026-02-10)
- 百融钱小乐:以科技践初心 协同赋能金融服务新体验(2026-02-09)
- 钨钼铸基,纯钛入心――陕西东吉金属科技的稀有金属创新与纯钛生活新(2026-02-09)
- 多奖加身,领跑边缘云赛道:白山云科技实力铸就(2026-02-09)